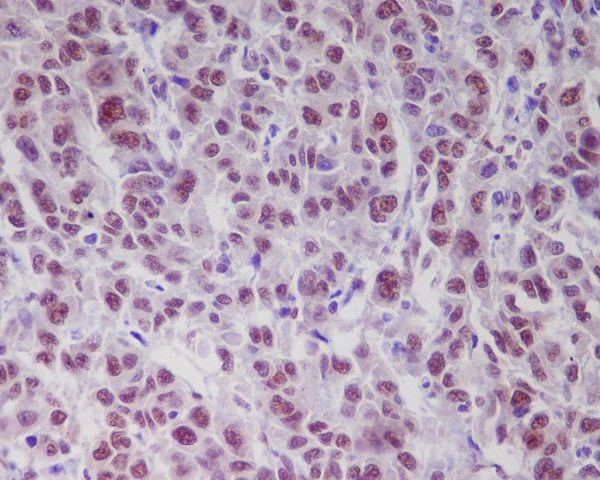
IHC - Anti-Phospho-ATM (S1981) Rabbit Monoclonal Antibody ABO13125

Anti-Phospho-ATM (S1981) Rabbit Monoclonal Antibody
- SPECIFICATION
- CITATIONS
- PROTOCOLS
- BACKGROUND

Application
| WB, IHC, IF, ICC, IP |
|---|---|
| Primary Accession | Q13315 |
| Host | Rabbit |
| Isotype | Rabbit IgG |
| Reactivity | Human |
| Clonality | Monoclonal |
| Format | Liquid |
| Description | Anti-Phospho-ATM (S1981) Rabbit Monoclonal Antibody . Tested in WB, IHC, ICC/IF, IP applications. This antibody reacts with Human. |
| Gene ID | 472 |
|---|---|
| Other Names | Serine-protein kinase ATM, 2.7.11.1, Ataxia telangiectasia mutated, A-T mutated, ATM |
| Calculated MW | 350687 MW KDa |
| Application Details | WB 1:500-1:2000 IHC 1:50-1:200 ICC/IF 1:50-1:200 IP 1:50 |
| Subcellular Localization | Nucleus. Cytoplasmic vesicle. Primarily nuclear. Found also in endocytic vesicles in association with beta-adaptin. |
| Tissue Specificity | Found in pancreas, kidney, skeletal muscle, liver, lung, placenta, brain, heart, spleen, thymus, testis, ovary, small intestine, colon and leukocytes. |
| Contents | Rabbit IgG in phosphate buffered saline, pH 7.4, 150mM NaCl, 0.02% sodium azide and 50% glycerol, 0.4-0.5mg/ml BSA. |
| Clone Names | Clone: AEE-1 |
| Immunogen | A synthesized peptide derived from human Phospho-ATM (S1981) |
| Purification | Affinity-chromatography |
| Storage | Store at -20°C for one year. For short term storage and frequent use, store at 4°C for up to one month. Avoid repeated freeze-thaw cycles. |
| Name | ATM |
|---|---|
| Function | Serine/threonine protein kinase which activates checkpoint signaling upon double strand breaks (DSBs), apoptosis and genotoxic stresses such as ionizing ultraviolet A light (UVA), thereby acting as a DNA damage sensor (PubMed:10550055, PubMed:10839545, PubMed:10910365, PubMed:12556884, PubMed:14871926, PubMed:15064416, PubMed:15448695, PubMed:15456891, PubMed:15790808, PubMed:15916964, PubMed:17923702, PubMed:21757780, PubMed:24534091, PubMed:35076389, PubMed:9733514). Recognizes the substrate consensus sequence [ST]-Q (PubMed:10550055, PubMed:10839545, PubMed:10910365, PubMed:12556884, PubMed:14871926, PubMed:15448695, PubMed:15456891, PubMed:15916964, PubMed:17923702, PubMed:24534091, PubMed:9733514). Phosphorylates 'Ser-139' of histone variant H2AX at double strand breaks (DSBs), thereby regulating DNA damage response mechanism (By similarity). Also plays a role in pre-B cell allelic exclusion, a process leading to expression of a single immunoglobulin heavy chain allele to enforce clonality and monospecific recognition by the B-cell antigen receptor (BCR) expressed on individual B-lymphocytes. After the introduction of DNA breaks by the RAG complex on one immunoglobulin allele, acts by mediating a repositioning of the second allele to pericentromeric heterochromatin, preventing accessibility to the RAG complex and recombination of the second allele. Also involved in signal transduction and cell cycle control. May function as a tumor suppressor. Necessary for activation of ABL1 and SAPK. Phosphorylates DYRK2, CHEK2, p53/TP53, FBXW7, FANCD2, NFKBIA, BRCA1, CREBBP/CBP, RBBP8/CTIP, FBXO46, MRE11, nibrin (NBN), RAD50, RAD17, PELI1, TERF1, UFL1, RAD9, UBQLN4 and DCLRE1C (PubMed:10550055, PubMed:10766245, PubMed:10802669, PubMed:10839545, PubMed:10910365, PubMed:10973490, PubMed:11375976, PubMed:12086603, PubMed:15456891, PubMed:19965871, PubMed:21757780, PubMed:24534091, PubMed:26240375, PubMed:26774286, PubMed:30171069, PubMed:30612738, PubMed:30886146, PubMed:30952868, PubMed:38128537, PubMed:9733515, PubMed:9843217). May play a role in vesicle and/or protein transport. Could play a role in T-cell development, gonad and neurological function. Plays a role in replication-dependent histone mRNA degradation. Binds DNA ends. Phosphorylation of DYRK2 in nucleus in response to genotoxic stress prevents its MDM2-mediated ubiquitination and subsequent proteasome degradation (PubMed:19965871). Phosphorylates ATF2 which stimulates its function in DNA damage response (PubMed:15916964). Phosphorylates ERCC6 which is essential for its chromatin remodeling activity at DNA double-strand breaks (PubMed:29203878). Phosphorylates TTC5/STRAP at 'Ser-203' in the cytoplasm in response to DNA damage, which promotes TTC5/STRAP nuclear localization (PubMed:15448695). Also involved in pexophagy by mediating phosphorylation of PEX5: translocated to peroxisomes in response to reactive oxygen species (ROS), and catalyzes phosphorylation of PEX5, promoting PEX5 ubiquitination and induction of pexophagy (PubMed:26344566). |
| Cellular Location | Nucleus. Cytoplasmic vesicle. Cytoplasm, cytoskeleton, microtubule organizing center, centrosome {ECO:0000250|UniProtKB:Q62388}. Peroxisome matrix. Note=Primarily nuclear (PubMed:9050866, PubMed:9150358). Found also in endocytic vesicles in association with beta-adaptin (PubMed:9707615). Translocated to peroxisomes in response to reactive oxygen species (ROS) by PEX5 (PubMed:26344566) |
| Tissue Location | Found in pancreas, kidney, skeletal muscle, liver, lung, placenta, brain, heart, spleen, thymus, testis, ovary, small intestine, colon and leukocytes |

Thousands of laboratories across the world have published research that depended on the performance of antibodies from Abcepta to advance their research. Check out links to articles that cite our products in major peer-reviewed journals, organized by research category.
info@abcepta.com, and receive a free "I Love Antibodies" mug.
Provided below are standard protocols that you may find useful for product applications.
If you have used an Abcepta product and would like to share how it has performed, please click on the "Submit Review" button and provide the requested information. Our staff will examine and post your review and contact you if needed.
If you have any additional inquiries please email technical services at tech@abcepta.com.





Foundational characteristics of cancer include proliferation, angiogenesis, migration, evasion of apoptosis, and cellular immortality. Find key markers for these cellular processes and antibodies to detect them.
The SUMOplot™ Analysis Program predicts and scores sumoylation sites in your protein. SUMOylation is a post-translational modification involved in various cellular processes, such as nuclear-cytosolic transport, transcriptional regulation, apoptosis, protein stability, response to stress, and progression through the cell cycle.
The Autophagy Receptor Motif Plotter predicts and scores autophagy receptor binding sites in your protein. Identifying proteins connected to this pathway is critical to understanding the role of autophagy in physiological as well as pathological processes such as development, differentiation, neurodegenerative diseases, stress, infection, and cancer.